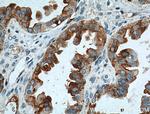
MSLN Antibody in Immunohistochemistry (Paraffin) (IHC (P))

Search
Proteintech
MSLN Monoclonal Antibody (2E3A4)
{{$productOrderCtrl.translations['antibody.pdp.commerceCard.promotion.promotions']}}
{{$productOrderCtrl.translations['antibody.pdp.commerceCard.promotion.viewpromo']}}
{{$productOrderCtrl.translations['antibody.pdp.commerceCard.promotion.promocode']}}: {{promo.promoCode}} {{promo.promoTitle}} {{promo.promoDescription}}. {{$productOrderCtrl.translations['antibody.pdp.commerceCard.promotion.learnmore']}}
产品信息
66404-1-IG
种属反应
宿主/亚型
分类
类型
克隆号
抗原
偶联物
形式
浓度
纯化类型
保存液
内含物
保存条件
运输条件
产品详细信息
Immunogen sequence: RSSRDPSWR QPERTILRPR FRREVEKTAC PSGKKAREID ESLIFYKKWE LEACVDAALL ATQMDRVNAI PFTYEQLDVL KHKLDELYPQ GYPESVIQHL GYLFLKMSPE DIRKWNVTSL ETLKALLEVN KGHEMSPQVA TLIDRFVKGR GQLDKDTLDT LTAFYPGYLC SLSPEELSSV PPSSIWAVRP QDLDTCDPRQ LDVLYPKARL AFQNMNGSEY FVKIQSFLGG APTEDLKALS QQNVSMDLAT FMKLRTDAVL PLTVAEVQKL LGPHVEGLKA EERHRPVRDW ILRQRQDDLD TLGLGLQGGI PNGYLVLDLS VQEALSGTPC LLGPGPVLTV LALLLASTLA (273-621 aa encoded by BC003512)
靶标信息
Originally identified as a differentiation antigen of mesotheliomas, ovarian cystadenocarcinomas, and pancreatic adenocarcinomas, Mesothelin is a glycosylphosphatidylinositol (GPI)-anchored, cell-surface glycoprotein predominantly secreted by cells of the mesothelium. Although Mesothelin is expressed at restricted levels by normal mesothelial cells of the pleural,pericardial, and peritoneal membranes, aberrant expression has been documented in the aforementioned cancers, as well as in endometriod uterine adenocarcinomas and squamous cell carcinomas of the esophagus, stomach, lung, and cervix. Proteolytic cleavage of Mesothelin yields a soluble, polypeptide fragment designated megakaryocyte potentiating factor (MPF) based on its ability to stimulate megakaryocyte colony-forming activity of murine interleukin-3 in murine bone marrow cell cultures. Originally isolated from the HPC-Y5 pancreatic cell line, MPF has been suggested to play a role in the proliferation and differentiation of megakaryoctyes, and the regulation of resultant platelet production. While the biological functions of both Mesothelin and MPF remain speculative, high-levels of expression in cancerous tissues compared to limited distribution in normal tissues strongly suggests their involvement in tumorigenesis. Both have been demonstrated to promote tumor cell proliferation, migration,anchorage-independent growth, and tumor progression; demonstrating their involvement in heterotypic cell adhesion and the metastatic spread of cancer.
仅用于科研。不用于诊断过程。未经明确授权不得转售。
篇参考文献 (0)
生物信息学
蛋白别名: CAK1; CAK1 antigen; megakaryocyte potentiating factor; Mesothelin; Pre-pro-megakaryocyte-potentiating factor; SMR; soluble MPF mesothelin related protein
基因别名: MPF; MSLN; SMRP
UniProt ID: (Human) Q13421
Entrez Gene ID: (Human) 10232